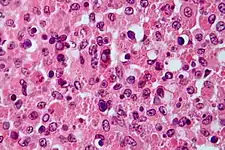

Malakoplakia
Malakoplakia (from Greek Malako "soft" + Plako "plaque") is a rare inflammatory condition which makes its presence known as a papule, plaque or ulceration that usually affects the genitourinary tract.[1]: 274 However, it may also be associated with other bodily organs. It was initially described in the early 20th century as soft yellowish plaques found on the mucosa of the urinary bladder. Microscopically it is characterized by the presence of foamy histiocytes (called von Hansemann cells) with basophilic inclusions called Michaelis–Gutmann bodies.
| Malakoplakia | |
|---|---|
| Other names | Malacoplakia |
![]() | |
| Micrograph showing the characteristic finding of malakoplakia (Michaelis–Gutmann bodies). H&E stain. | |
It usually involves gram-negative bacteria.[2]
Causes
Malakoplakia is thought to result from the insufficient killing of bacteria by macrophages. Therefore, the partially digested bacteria accumulate in macrophages and leads to a deposition of iron and calcium. The impairment of bactericidal activity manifests itself as the formation of an ulcer, plaque or papule. Malakoplakia is associated with patients with a history of immunosuppression due to lymphoma, diabetes mellitus, kidney transplantation, or because of long-term therapy with systemic corticosteroids.
Diagnosis
As malakoplakia is a condition associated with chronic cystitis, it usually presents itself as a cystitis condition. The following investigations may help in making the diagnosis of malakoplakia:
- Urinalysis which indicates presence of bacteria and white blood cells.
- Urine culture
- Cystoscopic evaluation confirms presence of ulcer or papule.
- Biopsy to rule out other causes.
- The presence of large multinucleated malakoplakia giant cells with concretions called as Michaelis Gutman bodies on microscopy.
Treatment
Treatments for malakoplakia include catheterizing the affected person with full aseptic precautions. Additionally, irrigating the bladder with distilled water three times daily with 3 way Foley's catheter and urinary antiseptics like pyridium may be used to help relieve urinary symptoms. Antibiotics such as trimethoprim-sulfamethoxazole or ciprofloxacin may be used.[3][4]
History
Leonor Michaelis and Carl Gutmann first described malakoplakia in 1902 after analyzing a patient's tumor at the request of David Paul von Hansemann.[5]
References
- James, William D.; Berger, Timothy G.; et al. (2006). Andrews' Diseases of the Skin: clinical Dermatology. Saunders Elsevier. ISBN 978-0-7216-2921-6.
- Liang Cheng; David G. Bostwick (2006). Essentials of anatomic pathology. Springer. pp. 1180–. ISBN 978-1-58829-461-6. Retrieved 15 May 2010.
- Simpson, Claire; Strong, Nicholas P.; Dickinson, Jane; Young, Fergus I.; Sandford-Smith, John H. (February 1992). "Medical Management of Ocular Malakoplakia". Ophthalmology. 99 (2): 192–196. doi:10.1016/s0161-6420(92)31993-1. PMID 1553207.
- van Furth, R.; van't Wout, J.W.; Zwartendijk, J.; Wertheimer, P.A. (January 1992). "Ciprofloxacin for treatment of malakoplakia". The Lancet. 339 (8786): 148–149. doi:10.1016/0140-6736(92)90212-l. PMID 1346012. S2CID 1436404.
- McClure J (August 1983). "Malakoplakia". J Pathol. 140 (4): 275–330. doi:10.1002/path.1711400402. PMID 6308195. S2CID 222083065.